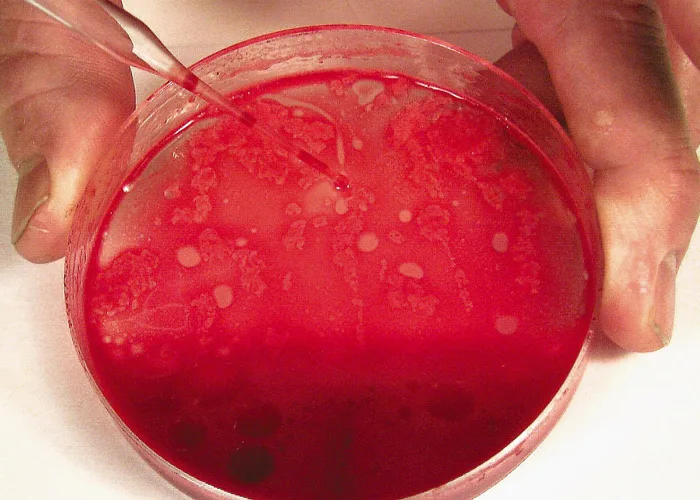

Bone Marrow Aspiration Biopsy
John W. Harvey, DVM, PhD, DACVP (Clinical Pathology), University of Florida

Overview
Bone marrow evaluation is indicated when certain peripheral blood abnormalities are detected. The most common indications are persistent neutropenia, unexplained thrombocytopenia, poorly regenerative anemia, or a combination thereof. Examples of proliferative abnormalities in which bone marrow examination may be indicated include persistent thrombocytosis or leukocytosis, abnormal morphologic characteristics of blood cells, or the unexplained presence of immature cells in blood (e.g., nucleated erythroid cells in the absence of polychromasia or neutrophilic left shift in the absence of inflammation).
Bone marrow is sometimes examined to stage neoplastic conditions (lymphomas and mast cell tumors), estimate the adequacy of body iron stores, and evaluate lytic bone lesions. Bone marrow examination can also be useful in determining the cause of hyperproteinemia secondary to multiple myeloma, lymphoma, leishmaniasis, and systemic fungal diseases. It may also reveal the cause of a hypercalcemia when associated with lymphoid neoplasms, multiple myeloma, or neoplasms that have metastasized to bone.
Aspiration Versus Core Biopsy
Bone marrow aspiration biopsy is done more frequently than bone marrow core biopsy in veterinary patients because it is easier, faster, and less expensive to perform. Bone marrow core biopsy requires special needles that cut a solid core of material that is then placed in fixative, decalcified, embedded, sectioned, stained, and examined microscopically by a pathologist. Core biopsy sections are more accurate for evaluating marrow cellularity and examining for metastatic neoplasia than are aspirate smears, but the morphologic characteristics of cells are more difficult to assess. Bone marrow core biopsy must be done when repeated "dry taps" occur during attempts at aspiration, and it is the only method of definitive diagnosis of myelofibrosis. Core biopsy may also be needed to confirm the presence of inflammation within the marrow.
Bone marrow aspiration biopsy has few contraindications. Postbiopsy hemorrhage may occur in patients with hemostatic diatheses but is rare. It may also occur in animals with monoclonal hyperglobulinemia, but this is easily controlled by placing a suture in the skin incision and applying pressure over the biopsy site. Postbiopsy infection is also a potential complication but is very unlikely if proper techniques are used.
This presentation addresses collection and preparation of smears of bone marrow aspirate. Sterile needles, syringes, and gloves are always used, but the aspiration site does not have to be draped. If general anesthesia is required for other procedures, bone marrow aspiration may be scheduled at the same time to minimize the stress on the animal. Most animals are tranquilized before bone marrow biopsy.
Biopsy Sites
Active marrow is present in the flat bones (vertebrae, sternum, ribs, and pelvis) and proximal ends of the humerus and femur in adults.
Iliac Crest & Femur
The iliac crest is often used as a site for marrow biopsy in dogs and cats. The biopsy needle is positioned so that it enters the greatest prominence of the iliac crest parallel to the long axis of the wing of the ilium. The wing of the ilium may also be aspirated at the central depression of the wing caudal and ventral to the iliac crest (Figure A).

For small cats and toy breeds of dogs, in which the ilium is especially thin, the marrow may be aspirated from the head of the proximal femur by way of the trochanteric fossa.
Humerus
Aspiration of marrow from the anterior side of the proximal end of the humerus is another popular site, especially in obese patients. The greater tubercle is palpated, and the needle is inserted into the flat area on the craniolateral surface of the proximal humerus distal to the tubercle (Figure B).

Sternum
In large dogs, biopsy can be done on the third, fourth, or fifth sternebra. Biopsy of the sternum is associated with risk for inadvertent penetration of the thorax and damage to structures in the thoracic cavity. A short biopsy needle (preferably with an adjustable guard) should be used, and care should be taken to remain in the center of these bones to minimize the risk for pneumothorax, uncontrolled hemorrhage, and cardiac laceration. Biopsy samples may be taken from other sites if specific lesions are identified using diagnostic imaging.
How to Perform an Aspiration Biopsy
Getting Started
It is good practice to set out the equipment close to where the procedure will be done. See below for a list of necessary equipment.
What You Will Need
A 16- or 18-gauge biopsy needle between 1 and 1.5 inches long with stylet in place and adjustable guard (see Figure C) to limit depth of penetration. Needles used to aspirate marrow must have a removable stylet, which remains in place until the marrow cavity is entered to prevent obstruction of the needle lumen with cortical bone.
6- to 12-ml syringe containing several drops of 5% EDTA
Several glass slides on a slide tray
Petri dish and pipette

Step 1
Prepare the site by clipping the hair and scrubbing the skin with antiseptic soap.

Step 2
Inject a local anesthetic under the skin and down to the periosteum overlying the biopsy site. Make a small skin incision with a scalpel blade to facilitate passing the needle through the skin.
Procedure Pearl
Bone marrow biopsy has few contraindications or complications.

Step 3
To enter the marrow space, apply moderate pressure to the needle (with the stylet locked in place) and rotate the needle in an alternating clockwise-counterclockwise motion. Once the needle is firmly embedded into the bone, it is usually within the marrow cavity.

Step 4
Remove the stylet and attach the syringe to the needle. Vigorously apply negative pressure by rapidly pulling the plunger back several times in a pumping motion.
Procedure Pearl
Postbiopsy hemorrhage is easily controlled by placing a suture in the skin incision and applying pressure over the site.

Step 5
Once red marrow appears in the syringe, release the negative pressure, rapidly remove the complete assembly, and mix by rotating the syringe back and forth. If marrow does not appear in the syringe, replace the stylet and reposition the needle for another attempt.

Slide Preparation
Smears do not have to be made immediately when collected with EDTA, but they should be prepared within minutes after collection because bone marrow cells (especially granulocytic cells) degenerate rapidly. After mixing the aspirated marrow with the anticoagulant, remove the needle and expel the marrow into a Petri dish. For accurate bone marrow evaluation, smears must contain marrow particles (stroma and associated cells). Marrow particles appear as small, white grains in the blood-contaminated aspirate material.
Step 6
Expel aspirated bone marrow containing anticoagulant into a Petri dish. Collect several particles with a pipette, micro-hematocrit tube, or tuberculin syringe and needle.
Step 7
Place on one end of a glass slide held vertically. Particles tend to stick to the slide while blood runs off.

Step 8
Place a second glass slide across the area of particle adherence, perpendicular to the first slide. Hold the slides together until the marrow spreads; then pull them rapidly apart in the horizontal plane. Dry the smear immediately by waving it in the air or holding it in front of a hair dryer set on warm. Holding the slides close to a dryer set on hot can result in fragmentation of cells.
Procedure Pearl
Smears should be prepared with EDTA within minutes because bone marrow cells degenerate rapidly.

No-Anticoagulant Method
Bone marrow aspirates can be collected without anticoagulant in the syringe, but rapid clotting of the specimen is a concern. Clotting precludes diagnosis and the procedure will need to be repeated. When anticoagulant is not used, release the negative pressure as soon as red blood/marrow appears in the syringe. Remove the syringe with the needle attached from the bone, place one to two drops of specimen on each of multiple glass slides, and prepare the smears within seconds as illustrated in Steps 7 and 8.
Fix and stain the smears with a Romanowsky-type stain, such as Wright-Giemsa, or a combination thereof. Satisfactory results can usually be obtained with Diff-Quik stain, a rapid, modified Wright stain. Appropriate staining time for the stain used is determined with experience. Thicker smears require longer times. Staining bone marrow takes about twice as long as staining blood. Smears containing marrow particles will have blue-staining material on them, which is visible grossly. (See Figure D.) The scant blue-staining material in the bottom smear indicates that only a few, small marrow particles are present. The abundant blue-staining material in the top smear indicates that a large amount of bone marrow is present.

If more than one smear can be made, submit one for an iron stain. If leukemia is suspected or identified on the routine stained specimen, the additional slides can be used for special characterizing stains.